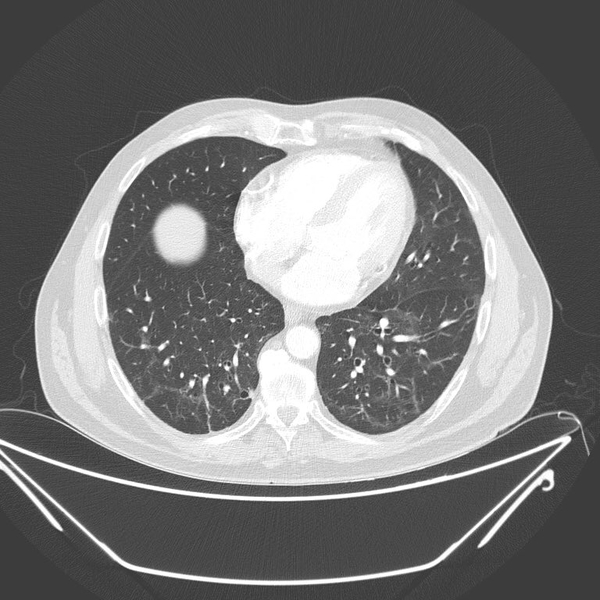

Koronavirüs tedavisi kanseri iyileştiriyor mu? Tomografi çekimlerinde şoke eden durum
Dünyayı adeta ele geçiren koronavirüs tedavisinde kullanılan yöntemler kansere umut mu oluyor? İlk olarak 2019 Aralık ayında ortaya çıkan ve giderek yayılan yeni tip koronavirüs dünya genelinde milyonlarca kişiye bulaştı. Dünya koronavirüsle savaşırken bu kez lenfoma hastalarına umut oldu. Koronavirüsle mücadele eden hücrelerin lenf kanseri hücrelerini yok ettiği ortaya çıktı. İşte detaylar...


Türkiye'de son 24 saatte 138 bin 592 Kovid-19 testi yapıldı, 11 bin 770 kişinin Kovid-19 testi pozitif çıktı, 64 kişi hayatını kaybetti. Türkiye Günlük Koronavirüs Tablosu, "covid19.saglik.gov.tr" adresinden paylaşıldı.

Buna göre, son 24 saatte 138 bin 592 Kovid-19 testi yapıldı, 11 bin 770 kişinin Kovid-19 testi pozitif çıktı, 64 kişi yaşamını yitirdi, hasta sayısı 702 oldu. Son 24 saatte 7 bin 291 kişinin Kovid-19 tedavisi ya da karantinasının sona ermesiyle iyileşen sayısı 2 milyon 616 bin 139'a yükseldi.

Test sayısı 33 milyon 993 bin 552'ye ulaştı. Vaka sayısı 2 milyon 769 bin 230, vefat sayısı 28 bin 965, ağır hasta sayısı 1230 oldu.
Haftalık verilere göre, bu hafta hastalarda zatürre oranı yüzde 3,6, yatak doluluk oranı yüzde 49,1, erişkin yoğun bakım doluluk oranı yüzde 63,2, ventilatör doluluk oranı yüzde 28,3, ortalama temaslı tespit süresi 8 saat, filyasyon oranı yüzde 99,9 olarak kayda geçti.

KORONAVİRÜS TEDAVİSİ
Yeni tip koronavirüs nedeniyle oluşan Covid-19 hastalığının tedavisinde doktorlar tarafından çeşitli antiviral ajanlar ve sıtma veya diğer bazı hastalıkların tedavisinde kullanılan klorokin türevi ilaçlar reçetelendirilebilir.

Acil ve gerekli durumlar halinde daha önce hastalığı geçirmiş, iyileşmiş ve kan dolaşımında yeni tip koronavirüse karşı antikorlara sahip kişilerin bağışladığı plazma tedavi amacıyla hasta kişilerde kullanılabilir.

Ağrı kesiciler, öksürük semptomu ile ilgili kontrol sağlayıcı ilaçlar, dinlenme ve düzenli sıvı tüketimi covid-19 hastalığına dair destek tedavisi içerisinde değerlendirilen uygulamalar arasında yer alır.

KORONAVİRÜS TEDAVİSİ KANSERİ BİTİRİYOR MU?
Öte yandan koronavirüs tedavisinde kullanılan yöntemlerin dünyanın en belalı hastalığı olan kansere umut olduğu ortaya çıktı.
Prof. Dr. Güner Sönmez, "Evre 4 akciğer kanseri hastanın Covid 19 öncesi ve sonra çekilen akciğer tomografisi.
Akciğerdeki metastaz kaybolmuş. Daha önce de bir lenfoma hastasını paylaşmıştım; Covid sonrası tamamen lenfoma bulguları kaybolmuştu.

Muhtemelen Corona virüse karşı oluşan antikorlar ve hücresel bağışıklık, kanser hücrelerine de müdahale ediyor." ifadelerini kullandı.

Sönmez, "61 yaşında erkek hastaya lenf bezelerinin şişmesi üzerine biyopsi yapılıyor ve Hodgkin lenfoma (lenf kanseri) tanısı konuyor. Bu tanıdan hemen sonra da #COVID19 oluyor. Kanser tedavisi-kortizon verilmiyor. 4 ay sonra lenfomanın iyileştiği görülüyor. İlk çekilen PET/CT ve 4. ay" dedi.

"KANSERLİ BÖLGE KENDİLİĞİNDEN İYİLEŞTİ"
Türk Tıbbi Onkoloji Derneği Başkanı Prof. Dr. Serdar Turhal, "Bugünlerde koronavirüs hastalığıyla ilgili her türlü bilgi onkoloji doktorları olarak bizimde ilgimizi çekiyor. Yakın zamanda İngiltere´de lenf kanseri teşhisi konulan ve sonrasında koronavirüse yakalanarak tedavi edilen yaşlı bir kişide, kansere ilişkin tedavi uygulanmamasına rağmen kanserli bölgenin kendiliğinden iyileştiği rapor edildi. Bu gözlemlerin arkası gelecek olursa koronavirüsle mücadele kapsamında geliştirilen bağışıklık sisteminin bazı tümörlerle mücadele etmesi ve onları yok etmesi kanser hastalarına yeni bir umut ışığı oldu" dedi.

"DİĞER KANSER TÜRLERİ İÇİN AYNI DURUM SÖZ KONUSU DEĞİL"
Türkiye´de kalın bağırsak, akciğer ve meme kanseri gibi türlerin daha sık görüldüğüne işaret eden Prof. Dr. Serdar Turhal, "Bağışıklık sisteminin tümör hücrelerine etki edebilmesi için tümör hücrelerinin hepsinin birbirine benziyor olması gerekiyor. Sık rastlanılan akciğer, kalın bağırsak ve meme kanserinde tümör hücreleri birbirine çok benzemez. Koronavirüse karşı geliştirilen bağışıklık sistemi bu tür kanser türlerinde başarılı olma ihtimali daha düşüktür. Bu konuda gözlemlerimize devam ediyoruz" diye konuştu.

HER 100 BİN KİŞİDE GÖRÜLEN VAKA ARTIŞI AÇIKLANDI
Sağlık Bakanı Fahrettin Koca, illere göre 27 Şubat-5 Mart'ta her 100 bin kişiye düşen yeni tip koronavirüs (Kovid-19) vakası sayılarını açıkladı.
Koca, Twitter hesabından, illere göre 27 Şubat-5 Mart'a ait her 100 bin kişiye düşen Kovid-19 vaka sayılarının bulunduğu haritayı paylaşarak, "Yüksek riskli illerimiz risklerini düşürmek için daha tedbirli olmalı. Normalleşme kontrollü gerçekleşmeli. Bu hafta ne kadar tedbirli olursak şehirlerimizin rengi ona uygun olarak şekillenecek. Mevcut avantajlarımızı kaybetmemek için daha dikkatli ve temkinli hareket etmeliyiz." değerlendirmesinde bulundu.

Bakan Koca'nın paylaştığı haritadaki verilere göre, Samsun her 100 bin kişiye 348,36 Kovid-19 vakası ile ülke genelinde en yüksek vaka sayısına sahip il oldu. Bu şehri 314,15 ile Sinop, 282,14 ile Giresun, 280,27 ile Ordu ve 228,82 ile Tokat izledi. Kovid-19 vaka sayısı her 100 bin kişide İstanbul'da 111,57, Ankara'da 54,83, İzmir'de 66,47 oldu. Haftalık verilere göre her 100 bin kişide en az vaka sayısının olduğu iller sırasıyla 5,35 ile Hakkari, 5,76 ile Şırnak, 8,87 ile Batman, 10,83 ile Uşak ve 10,88 ile Mardin oldu.

DÜNYA GENELİ KORONAVİRÜS
Vaka sayısı ABD'de 29 milyon 595 bine, Hindistan'da 11 milyon 204 bine, Brezilya'da 10 milyon 871 bine ve Rusya'da 4 milyon 312 bine ulaştı.
İran Cumhurbaşkanı Hasan Ruhani, salgında yeni dalga endişesi nedeniyle 21 Mart'ta başlayacak Nevruz Bayramı'nda yüksek ve orta riskli şehirlere yolculuğun yasaklandığını duyurdu.
İsveç'in başkenti Stockholm'de salgın nedeniyle alınan tedbirler protesto edildi. Kendilerine "Milenyum" ismini veren bir grup, virüse karşı alınan hafif önlemlerin de kaldırılmasını istedi. Sırbistan'da ilk Kovid-19 vakasının tespit edilmesinin üzerinden tam bir yıl geçerken, salgın durumunun kötüleşmesi üzerine ek tedbirler yürürlüğe girdi.

Japonya'da, ABD'li biyoteknoloji firması Moderna'nın geliştirdiği aşının kullanım onayı için başvuru yapıldı.
Malezya Bilim, Teknoloji ve Yenilik Bakanlığı, ülkede şimdiye kadar 2 milyonun üzerinde kişinin internet üzerinden aşılama için başvuru yaptığını açıkladı. Filistin Yönetimi, işgal altındaki Batı Şeria'daki Ramallah kentini ve köylerini, vaka sayılarındaki artış nedeniyle bir hafta süreyle giriş ve çıkışlara kapatma kararı aldı.
Hindistan'ın, salgınla mücadele kapsamında Gana'ya 50 bin doz aşı bağışladığı belirtildi. Nijerya Devlet Başkanı Muhammed Buhari ve Başkan Yardımcısı Yemi Osinbajo'ya, Dünya Sağlık Örgütünün (DSÖ) öncülük ettiği Kovid-19 Aşıları Küresel Erişim Programı (COVAX) tarafından dağıtılan aşı uygulandı. Sudan Sanayi Bakanı İbrahim Şeyh, Kovid-19 testinin pozitif çıktığını açıkladı. Paraguay'da yoğun bakımda olan Kovid-19 hastaları için gerekli ilaç ve ekipman eksikliği sebebiyle başlayan protestolar, Devlet Başkanı Mario Abdo Benitez karşıtı protestolara dönüştü.




















